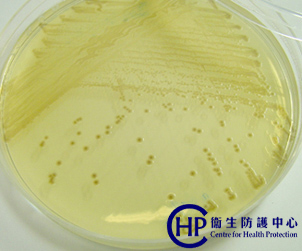

Good hygiene to prevent cholera
Feature Topic
Good hygiene to prevent cholera
2004-07-27
The Centre for Health Protection (CHP) of the Department of Health (DH) today (July 27) urged members of the public to be on guard against cholera following the detection of vibrio cholerae in fish tank water in local restaurants recently.
A CHP spokesman said cholera is active in summer. From previous cases, the transmission of cholera was mainly either through seafood which was not thoroughly cooked or cross contamination of food during the preparation process.
|
Vibrio cholerae |
"The best way to prevent the spread of cholera and other food-borne diseases is to observe good personal, food and environmental hygiene at all times," the spokesman said.
To-date four imported cholera cases were reported in Hong Kong this year. The figures for 2003, 2002 and 2001 were 7 (including 6 local cases), 4 (2 local cases) and 38 (25 local cases) respectively.
The spokesman reminded the public to:
* Clean and cook seafood thoroughly before eating, particularly crustaceans and bivalves such as shrimps, crabs, oysters and clams, and remove the viscera if appropriate;
* Wash hands before eating and after going to toilet;
* Handle raw and cooked food separately (upper compartment of the refrigerator for cooked food and lower compartment for raw food) to avoid cross contamination;
* Store food in refrigerator well covered (at 4 degrees Celsius or below) and thoroughly reheat leftover food before eating;
* Keep the environment clean.
When traveling outside Hong Kong:
* Always wash hands before eating and after going to toilet;
* Eat only thoroughly cooked food and food from sealed packs or cans;
* Avoid cold dishes such as salad and ice-cream;
* Drink only boiled water canned or bottled drinks, pasteurized milk or dairy products;
* Do not add ice to drinks and do not drink fresh fruit juice that has been prepared beforehand;
* Do not patronize illegal food hawkers; and
* Wash fruit thoroughly before eating and do not eat fruit that has already been peeled or cut open.
End/Tuesday, July 27, 2004
|